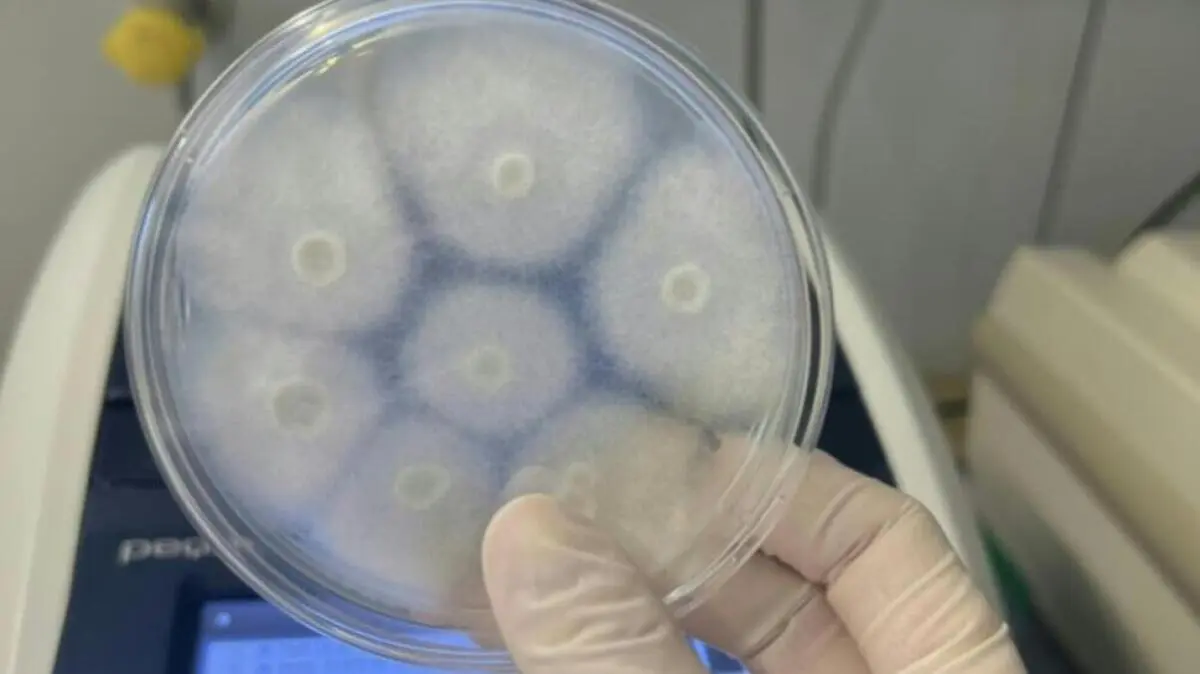

Innsbruck
Forscherin warnt vor Bedrohung bei Pilzbekämpfung
Die Innsbrucker Forscherin Michaela Lackner hat vor zunehmenden Resistenzen gegen Azole, einen zentralen Wirkstoff zur Bekämpfung von Pilzinfektionen, sowie der damit einhergehenden Bedrohung für Mensch, Tier und Umwelt gewarnt. Neben den besser erforschten antibakteriellen Resistenzen würden diese zunehmend zur Gefahr, betonte Lackner im APA-Gespräch. Sie forderte daher die Aufnahme von Antimykotika-Resistenzen in den globalen Aktionsplan gegen antimikrobielle Resistenzen.
© APA/MEDUNI INNSBRUCK